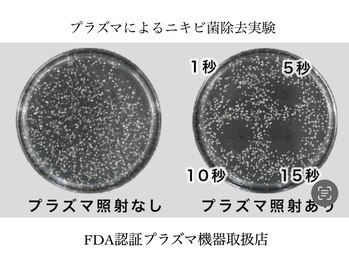
ルブラン(Lu'Bulan)/【プラズマシャワー取扱店】

ルブラン(Lu'Bulan)のクーポン
- 新規
- サロンに初来店の方
- 再来
- サロンに2回目以降にご来店の方
- 全員
- サロンにご来店の全員の方
|
全 員 |
¥0 【クーポンに迷った方はこちら】ご一緒にクーポンを選択☆施術時間のみご予約
|
|
新 規 |
¥12,000 ☆プレミアム毛穴洗浄☆【水素ハイドロピーリング&最新韓国3D毛穴洗浄】
|
|
新 規 |
¥13,000 【赤みの鎮静・乾燥による肌荒れ・ニキビ】本格9ステップ☆乳酸菌ピーリング
|
|
新 規 |
¥14,000 【毛穴開き・ニキビ肌リセット】本格9ステップ☆剥けないハーブピーリング☆
|
|
新 規 |
¥15,000 【シミ分解+シミ抑制+徹底美白】本格7ステップ☆高濃度ビタミンCピーリング
|
|
新 規 |
¥9,800 【韓国肌管理レベル1☆ツヤぷるん水光肌LHAララピール+超音波毛穴洗浄】
|